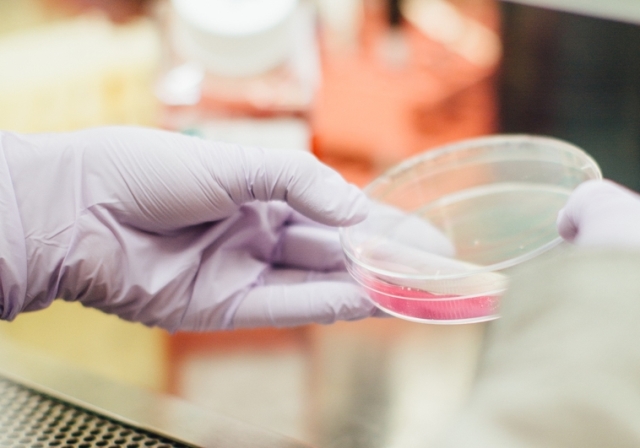
El trasplante fecal supera a los antibióticos en las infecciones bacterianas

Cáncer, cómo domesticar al emperador de todos los males
Julio 15 del 2025.-El objetivo más inmediato de la investigación oncológica es convertir el cáncer en una enfermedad crónica que nos permita convivir con ella sin comprometer nuestra vida. Pero…
¿Cómo quitar las manchas de óxido?
Julio 15 del 2025.-Aunque algo sea de «Acero Inoxidable» igual se puede llenar de óxido causado por el agua, ya que este tipo de material debe mantenerse seco en lo…
Prepara este fácil cóctel de camarones
Necesitaremos: Suscríbete a nuestro newsletter Recibe todas las noticias en tu casilla de e-mail. SUSCRIBIRSE 1 bandeja de camarones limpios y cocidos 1 pepino cortado en cubos 1/2 lb de…
¿Sabes que hablar por el móvil favorecer la hipertensión arterial?
«Lo que importa para la salud cardiaca es el número de minutos que las personas pasan hablando por el móvil, ya que un mayor tiempo significa un mayor riesgo», afirma…
La terapia combinada que ataca al cáncer de páncreas
Un tratamiento único que combina radiación e inmunoterapia puede erradicar los tumores de páncreas e impedir que el cáncer se extienda. Lo ha visto un estudio realizado por investigadores del…
Las mejores y peores dietas para el corazón: evita la keto y la paleo
¿Cuál es la dieta ideal para el corazón? Expertos en salud cardiovascular en EE.UU. han emitido una nueva declaración científica que, por primera vez, analiza en qué medida diez patrones…
La pastilla eléctrica que estimula el apetito para acabar con las náuseas
Las hormonas liberadas por el estómago, como la grelina, juegan un papel clave en la estimulación del apetito. Estas hormonas son producidas por células endocrinas que forman parte del sistema…
El trasplante fecal supera a los antibióticos en las infecciones bacterianas
La infección que causa la bacteria de clostridium difficile, caracterizada por diarrea, fiebre, náuseas y dolores abdominales, tiene como terapia más común los antibióticos; si embargo, cada vez hay más…
Fresas: la fruta deliciosa que también cuida tu salud
Julio 9 del 2025.-Las fresas no solo destacan por su sabor dulce y refrescante, sino también por sus múltiples beneficios para la salud. Gracias a su alto contenido de agua,…
¿Cómo mantener lejos a los mosquitos en época de lluvias? Dile adiós al zumbido y a las picaduras
Julio 9 del 2025.-Despídete del molesto zumbido de los mosquitos y duerme sin interrupciones durante los días de lluvia. Con la llegada de las lluvias, los mosquitos se multiplican y…